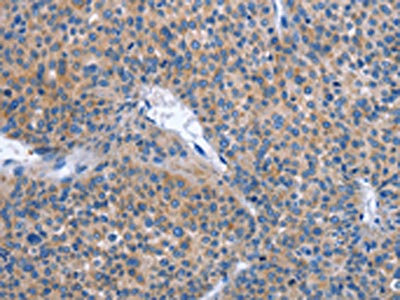

IBSP Antibody
-
中文名稱(chēng):IBSP兔多克隆抗體
-
貨號(hào):CSB-PA128816
-
規(guī)格:¥1100
-
圖片:
-
The image on the left is immunohistochemistry of paraffin-embedded Human liver cancer tissue using CSB-PA128816(IBSP Antibody) at dilution 1/30, on the right is treated with synthetic peptide. (Original magnification: ×200)
-
The image on the left is immunohistochemistry of paraffin-embedded Human colon cancer tissue using CSB-PA128816(IBSP Antibody) at dilution 1/30, on the right is treated with synthetic peptide. (Original magnification: ×200)
-
Gel: 8%SDS-PAGE, Lysate: 40 μg, Lane 1-3: Hela cells, K562 cells, hepG2 cells, Primary antibody: CSB-PA128816(IBSP Antibody) at dilution 1/350, Secondary antibody: Goat anti rabbit IgG at 1/8000 dilution, Exposure time: 10 seconds
-
-
其他:
產(chǎn)品詳情
-
Uniprot No.:
-
基因名:
-
別名:BNSP antibody; Bone sialoprotein 2 antibody; Bone sialoprotein II antibody; BSP antibody; BSP II antibody; BSPII antibody; Cell binding sialoprotein antibody; Cell-binding sialoprotein antibody; IBSP antibody; Integrin binding sialoprotein antibody; Integrin-binding sialoprotein antibody; SIAL_HUMAN antibody; SPII antibody
-
宿主:Rabbit
-
反應(yīng)種屬:Human,Mouse
-
免疫原:Synthetic peptide of Human IBSP
-
免疫原種屬:Homo sapiens (Human)
-
標(biāo)記方式:Non-conjugated
-
抗體亞型:IgG
-
純化方式:Antigen affinity purification
-
濃度:It differs from different batches. Please contact us to confirm it.
-
保存緩沖液:-20°C, pH7.4 PBS, 0.05% NaN3, 40% Glycerol
-
產(chǎn)品提供形式:Liquid
-
應(yīng)用范圍:ELISA,WB,IHC
-
推薦稀釋比:
Application Recommended Dilution ELISA 1:1000-1:2000 WB 1:200-1:1000 IHC 1:25-1:100 -
Protocols:
-
儲(chǔ)存條件:Upon receipt, store at -20°C or -80°C. Avoid repeated freeze.
-
貨期:Basically, we can dispatch the products out in 1-3 working days after receiving your orders. Delivery time maybe differs from different purchasing way or location, please kindly consult your local distributors for specific delivery time.
-
用途:For Research Use Only. Not for use in diagnostic or therapeutic procedures.
相關(guān)產(chǎn)品
靶點(diǎn)詳情
-
功能:Binds tightly to hydroxyapatite. Appears to form an integral part of the mineralized matrix. Probably important to cell-matrix interaction. Promotes Arg-Gly-Asp-dependent cell attachment.
-
基因功能參考文獻(xiàn):
- These data indicate that secretome derived from salivary gland cancer cells can influence the expression of two potential biomarkers of oral cancer-namely, bone sialoprotein (BSP) and dentin sialoprotein (DSP)-in normal salivary gland cells. PMID: 27881474
- In conclusion, serum levels of BSP, ALP, ICTP, and PSA increased in patients with bone metastases, and combined detection of all markers could improve the positive-predictive value. PMID: 27323113
- Preameloblast-Derived Factors Mediate Osteoblast Differentiation of Human Bone Marrow Mesenchymal Stem Cells by Runx2-Osterix-BSP Signaling. PMID: 26413977
- Two significant SNPs within IBSP, rs1054627 and rs17013181, were associated with BMD and postmenopausal osteoporosis by the two-stage strategy, and rs17013181 was also significantly associated with serum IBSP levels. PMID: 26568273
- Our results suggest that SSEA-4 is a specific cell surface antigen that can be used to identify dental pulp stem cells. PMID: 22266579
- the strong correlation between bone sialoprotein and OPN and papillary thyroid carcinoma suggests a role for BSP and OPN in calcification and tumor progression of papillary thyroid carcinoma PMID: 25973097
- oxidized low-density lipoprotein-induced expression dependent on Runx2 expression PMID: 25504218
- Bone sialoprotein could be a key mediator of the hypertrophic chondrocytes-induced angiogenesis of osteoarthritis. PMID: 24530278
- Current evidence demonstrates that BSP and OPN, play significant roles in bone metastasis of osteotropic malignancies derived from breast, prostate, lung, thyroid, and multiple myeloma. [review] PMID: 24071501
- High expression of bone sialoprotein in breast neoplasms was associated with cytokeratin-positive cells in bone marrow, but not with lymph node metastasis. PMID: 23726130
- results indicate that FGF2 increases BSP transcription by targeting the FRE and AP1 elements in the proximal promoter of the human BSP gene. PMID: 23485603
- BSP silencing decreased the integrin alphavbeta3 and beta3 levels, in turn inhibiting cell migration and invasion and decreasing the ability of the cells to metastasize to bone. PMID: 23667544
- IBSP mRNA is over expressed in carotid atheroma plaque (3.74 fold, p = 1.41E-09) in an intraindividual comparison. PMID: 23314561
- High BSP expression occurs in a significant subset of high-grade glioma patients and predicts a poorer outcome PMID: 23119009
- HTRA1 has a central role in osteogenesis through modification of proteins within the extracellular matrix, in particular, ibsp. PMID: 22865667
- human primary cementoblasts subjected to compression and IL-1beta stimulation impeded BSP and CEMP-1 expression, proteins that are associated with cementogenesis. PMID: 22349547
- OPN plasma levels are associated with the genetic polymorphisms in integrin-binding sialoprotein gene locus (IBSP) PMID: 20967421
- BSP protein expression in the primary resected non-small-cell lung cancer is strongly associated with bone metastasis and could be used to identify high-risk patients. PMID: 19376608
- RT-PCR analysis of human bone marrow stromal cells during osteogenesis in vitro: the mRNA levels of bone morphogenetic protein-2 (BMP-2), bone sialoprotein-II (BSP), osteopontin (OP) and cbfa-1 increased with culture time in osteogenic medium. PMID: 11968014
- has RGD sequence, affinity to collagen, and induces mineral crystal formation PMID: 11979972
- Osteoblast-related transcription factors Runx2 (Cbfa1/AML3) and MSX2 mediate the expression of bone sialoprotein in human metastatic breast cancer cells. PMID: 12750290
- BSP is expressed in breast and prostate cancer and has a role as a stimulator of bone mineralisation PMID: 14524533
- The time course of the expression of BSP wss visualized after dental implnt implatation in mandibular bone fibroblasts. PMID: 15795688
- Data show that RUNX2 is a direct regulator of bone sialoprotein in osteoblasts and that it functions in cooperation with DLX5 or a related factor to activate osteoblast-specific gene expression. PMID: 16000302
- Bone sialoprotein is involved in migration of bone marrow stromal cells through Matrigel and collagen barriers. PMID: 16995818
- bone sialoprotein expression in the primary resected NSCLC is strongly associated with BM progression and could be useful in identifying high-risk patients who could benefit from novel modalities of surveillance and preventive treatment PMID: 17050866
- May be a prognostic marker for bone metastasis in breast cancer. PMID: 17213971
- Runx2 and HDAC3 repress BSP gene expression and that this repression is suspended upon osteoblastic cell differentiation. PMID: 17956871
- has an angiogenic capacity; important in the differentiation of osteoblasts, bone matrix mineralization and tumor metastasis [review] PMID: 18302613
- PTH stimulates human BSP gene transcription by targeting the two cAMP response elements in the promoter of the human BSP gene. PMID: 19127545
- Studies do not support a role for BSP in promoting metastasis through interactions with pro-MMP-2. PMID: 19386107
- cooperative mechanisms by which BSP can enhance specific factors associated with a metastatic phenotype in tumor cell lines, an effect that is increased by circulating TGF-beta1 and EGF. PMID: 19492334
- Eight threonines modified by O-glycans were identified, leaving the C terminus of the protein free of glycans. The recombinant protein showed similar secondary structures as bone-derived BSP PMID: 11459848
顯示更多
收起更多
-
亞細(xì)胞定位:Secreted.
-
數(shù)據(jù)庫(kù)鏈接:
Most popular with customers
-
-
Phospho-YAP1 (S127) Recombinant Monoclonal Antibody
Applications: ELISA, WB, IHC
Species Reactivity: Human
-
-
-
-
-
-